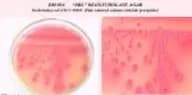
Deoxycholate Agar

Cell Culture Reagents
In this section, you will find a comprehensive selection of compounds and reagents essential for performing various cell cultures. These cell culture reagents are crucial for advancing research in microbiology and life sciences. They include media, supplements, growth factors, sera, and other additives necessary to create optimal conditions for cell growth, differentiation, and maintenance. Cell cultures are fundamental tools in studying cellular processes, drug development, genetic engineering, and disease mechanisms. At CymitQuimica, we offer high-quality reagents tailored to meet the specific requirements of different cell types and research applications, ensuring reliable and reproducible results in your cell culture experiments.
Found 1269 products of "Cell Culture Reagents"
Sort by
Purity (%)
0
100
|
0
|
50
|
90
|
95
|
100
Listeria Oxford Medium Base (Oxford Agar)
Color and Shape:Biege, Free flowing, homogeneous powder, Clear to slightly opalescent gel with a bluish tinge, Clear to slightly opalescent gel with a bluish tinge, Dark amberIMViC Test Kit (Pre-Weighed Media)
Color and Shape:Light cream, free flowing, homogeneous powder, Light amber,clear, Cream, free flowing, homogeneous powder, Light amber,clear, Mustard yellow, free flowing, homogeneous powder, Forest green, clear to slightly opalescentMacConkey Agar, Harmonized
Color and Shape:Pinkish beige, Free flowing, homogeneous powder, Very slightly opalescent, Clear to very slightly opalescent, Reddish purpleMeat Peptone Type T BactoBio for bacteriology
Color and Shape:Beige, Free flowing,homogeneous powder, Medium amber,clearCetrimide Broth (USP Basis)
Color and Shape:Yellow, Free flowing, homogeneous powder, Clear to very slightly opalescent without any precipitate, Clear to very slightly opalescent without any precipitate, YellowAlternative Thioglycollate Medium (IP, USP Basis)
Color and Shape:Beige to tan, Free flowing, homogeneous powder, Clear to very slightly opalescent may have slight precipitate, Clear to very slightly opalescent may have slight precipitate, Light amberDextrose Starch Agar
Color and Shape:Cream, Free flowing, homogeneous powder, Light amber, Slightly opalescent gel containing flocculent precipitateM9 Minimal Salts 5X
Color and Shape:White to off-white, Free flowing, homogeneous powder, Clear with no significant precipitate, ColourlessKing’s Medium B Base
Color and Shape:Cream to yellow, Free flowing, homogeneous powder, Clear to slightly opalescent, Clear to slightly opalescent, Light yellowPotato Dextrose Agar w/ Chloramphenicol (0.1g/lit ) (PDA w/ 0.01% Chloramphenicol)
Color and Shape:Light cream, Free flowing, homogeneous powder, Very slightly opalescent, Very slightly opalescent, Light amberSoyabean Casein Digest Medium (SCDM) (Tryptone Soya Broth, TSB) BioVeg
Color and Shape:Light cream, Free flowing, homogeneous powder, Clear without any precipitate, Clear without any precipitate, Light amberCeftriaxone Disodium Salt Hemiheptahydrate (CFTZ) for cell culture, Endotoxin (BET) 0.2EU/mg
CAS:Formula:C18H16N8Na2O7S3·5H2OMolecular weight:661.60Malt Extract Broth Base
Color and Shape:Light beige, Free flowing, homogeneous powder, Light amber, Clear without any precipitateAshby’s Glucose Agar
Color and Shape:Off white, Free flowing, homogeneous powder, Opalescent, Slightly opalescent, WhitishPikovskaya's Agar
Color and Shape:Off- white, Free flowing, homogeneous powder, White,w/ flocculant precipitate, Flocculant precipitate, WhiteViolet Red Bile Broth
Color and Shape:Biege, Free flowing, homogeneous powder, Clear, Clear, Reddish purpleAntibiotic Assay Medium No. 8 (Base Agar w/Low pH)
Color and Shape:Beige, Free flowing, homogeneous powder., Slightly opalescent, Very Slightly opalescent., Light to medium amber.CLED Agar w/ Andrade Indicator
Color and Shape:Beige with pinkish tint, Free flowing, homogeneous powder, Clear to slightly opalescent, Clear to very slightly opalescent, Greenish blueViolet Red Bile Dextrose Agar BioVeg
Color and Shape:Biege, Free flowing, homogeneous powder, Clear to slightly opalescent, Clear to slightly opalescent, Reddish purpleStreptococcus Thermophilus Isolation Agar
Color and Shape:Cream to yellow, Free flowing, homogeneous powder, Clear to slightly opalescent, Clear to very slightly opalescent, Light amberEnterococcus Confirmatory Agar
Color and Shape:Beige, Free flowing, homogeneous powder, Slightly opalescent, Slightly opalescent gel forms in tubes which acquires greenish tinge at the surface on standing, Light amberLysine Iron Agar
Color and Shape:Biege with greyish tinge, Free flowing, homogeneous powder, Clear to slightly opalescent, Clear to slightly opalescent, PurpleMeat Extract Powder BioVeg BactoBio for bacteriology
Color and Shape:Brownish yellow, Free flowing, homogeneous powder, Yellowish biege, ClearNitrate Broth (ISO, BIS Basis)
Color and Shape:Beige, Free flowing, homogeneous powder, Light to medium amber, ClearTodd Hewitt Broth
Color and Shape:Light beige, Free flowing, homogeneous powder, Clear, Clear without any precipitate, Light to medium amberBrain Heart Infusion Powder (BHI Powder) BactoBio for bacteriology
Color and Shape:Light tan, Free flowing, homogeneous powder, (2%) Light to medium amber, clearTryptone Broth BioVeg (Tryptone Water BioVeg)
Color and Shape:Light cream, Free flowing, homogeneous powder, Clear without any precipitate, Clear without any precipitate, Light amberCephotaxime Sodium Salt (CFT) for cell culture, 916-964ug/mg, Endotoxin (BET) 0.20EU/mg
CAS:Formula:C16H16N5NaO7S2Purity:916 - 964 µg/mgColor and Shape:Off-white to pale yellow, Crystalline powder, ClearMolecular weight:477.45Brain Heart Infusion w/ PABA and Agar (BHI Agar w/PABA)
Color and Shape:Beige, Free flowing, homogeneous powder, Light amber, Clear to slightly opalescent without any precipitateCLED Agar
Color and Shape:Biege with slight green tint, Free flowing, homogeneous powder, Very slightly opalescent, Very slightly opalescent, GreenNeopeptone BactoBio for bacteriology
Color and Shape:Beige to Tan, Free ,flowing homogeneous powder, Light to medium amber, clearNutrient Broth w/ 1% Yeast Extract
Color and Shape:Biege, Free flowing, homogeneous powder, Completely soluble, clear without any precipitate, Completely soluble, clear without any precipitate, CreamTRICINE Buffer for cell culture, 99%, Endotoxin (BET) 0.1EU/mg
CAS:Formula:C6H13NO5Purity:min. 99%Color and Shape:White, Crystalline powder, Clear, ColourlessMolecular weight:179.18Letheen Agar
Color and Shape:Beige, Free flowing, homogeneous powder, Clear to slightly opalescent, Clear to slightly opalescent, Medium amberL-Threonine for cell culture, 99%, Endotoxin (BET) 1EU/mg
CAS:Formula:C4H9NO3Purity:min. 99%Color and Shape:White to off white, Crystalline powder, Clear, Colourless to pale yellowMolecular weight:119.12Gelatin Powder Special ex. Porcine (Type B), 120g Bloom BactoBio for bacteriology
CAS:Color and Shape:Light yellow, granular powder, Clear to very slightly opalescentChroMed Listeria Ottaviani -Agosti Agar Base (ISO basis)
Color and Shape:Cream to yellow, Free flowing, homogeneous powder, Light amber, OpalescentPhenol Red Broth Base
Color and Shape:Light yellow to pink, Free flowing, homogeneous powder, Clear, Clear, RedPseudomonas Agar Base (ISO Basis)
Color and Shape:Light cream, Free flowing, homogeneous powder, Clear to slightly opalescent, Clear to very slightly opalescent, Light amberModified Skim Milk Agar (Modified SM Agar)
Color and Shape:Cream, Free flowing, homogeneous powder, Clear to very slightly opalescent, Clear to very slightly opalescent, Light to medium amberMueller Kauffman Tetrathionate Broth Base
Color and Shape:Biege, Free flowing, homogeneous powder, Opalescent with heavy white precipitate., Opalescent with heavy white precipitate., Light greenBile Esculin Azide Agar
Color and Shape:Light beige, Free flowing, homogeneous powder, Clear to opalescent, without any precipitate, Clear to very slightly opalescent,without any precipitate, Amber, with a bluish tinge.Phleomycin (PLM) ex. Streptomyces verticillus for cell culture, Endotoxin (BET) 1.0EU/mg
CAS:Formula:C51H75N17O21S2Purity:80-120%Color and Shape:Blue, PowderMolecular weight:1326.37L-Glutamic Acid Monosodium Salt Monohydrate (MSG) for cell culture, 99%, Endotoxin (BET) 0.05EU/mg
CAS:Formula:C5H8NO4Na·H2OPurity:min. 99%Color and Shape:White, Needle shape compound / Crystalline powder, Clear, ColourlessMolecular weight:187.14GC Agar Base
Color and Shape:Light cream to yellow coloured, Free flowing, homogeneous powder, Clear to opalescent, Clear to slightly opalescent. After addition of Haemoglobin: Chocolate brown coloured opaque, Light to medium amber.Magnesium Sulphate Dried for cell culture, 62-70% MgSO4, 99%, Endotoxin (BET) 0.05EU/mg
CAS:Formula:MgSO4·xH2OPurity:min. 99%Color and Shape:White, Crystalline compound, Clear, ColourlessMolecular weight:120.37 (anhy)Schaedler Agar
Color and Shape:Beige, Free,flowing,homogeneous powder., Light amber, Clear to very slightly opalescentBlood Agar Base (w/o sheep blood)
Color and Shape:Yellow, Free flowing, homogeneous powder, Clear to slightly opalescent, Clear to very slightly opalescent, Light amber (Note : After addition of 5% sterile defibrinated sheep blood: Cherry red, opaque.)CAE Agar Base (Citrate Azide Enterococcus)
Color and Shape:Beige, Free flowing, homogeneous powder, Clear to slightly opalescent, Light to medium amber, Clear to slightly opalescentPlate Count Agar, Special
Color and Shape:Beige, Free flowing, homogeneous powder, Light yellow, Clear to slightly opalescentTryptophan Broth (Tryptophan Medium) (ISO Basis)
Color and Shape:Cream colour, Free flowing,homogeneous powder, Light to medium amber, Clear solution,without any precipitateBrain Heart Infusion Agar (BHI Agar)
Color and Shape:Light cream, Free flowing, homogeneous powder, Clear to slightly opalescent, Clear to slightly opalescent,Brilliant Green Bile Agar
Color and Shape:Light purple, Free flowing, homogeneous powder, Bluish purple, Very slightly opalescent. gelPeptone BioVeg BactoBio for bacteriology
Color and Shape:Light to medium tan, Free flowing, homogeneous powder, Light to medium amber, clearMeat Peptone Type P BactoBio for bacteriology
Color and Shape:Biege, Free flowing, homogeneous powder, Light to medium amber, clearCharcoal Agar
Color and Shape:Grey, Free flowing, homogeneous powder, Opaque solution with precipitate, Opaque with precipitate, BlackNutrient Broth BioVeg
Color and Shape:Light cream, Free flowing, homogenous powder, Clear without any precipitate, Clear without any precipitate, Light amberBushnell - Haas Agar
Color and Shape:White to light pink, Free flowing, homogeneous powder, Slightly opalescent, Slightly opalescent, Light amberChroMed Aureus Agar
Color and Shape:Light yellow, Free flowing, homogeneous powder, Clear to slightly opalescent, Clear to slightly opalescent, Light amberStrepto Supplement
<p>1. Aseptically add 2-5 ml of sterile 0.2 N Sodium Hydroxide to 1 vial.<br>2. Mix well and aseptically add to sterile cooled media at 45-50°C and pour in petriplates.<br>3. Add content of 1 vial to 500 ml of Columbia Blood Agar Base, Blood agar Base No.2 (67644), Chocolate Agar Base (28850).</p>Color and Shape:White, fine powderCiprofloxacin Hydrochloride Hydrate (CPFX) for cell culture, 98-102%, Endotoxin (BET) 0.05EU/mg
CAS:Formula:C17H18FN3O3·HCl·xH20Purity:98% - 102%Color and Shape:Pale yellow, Crystalline powder, Clear, Pale yellowMolecular weight:367.80Violet Red Bile Agar w/ MUG
Color and Shape:Pinkish to Reddish-beige, Free flowing, homogeneous powder, Clear to very slightly opalescent, Reddish- purpleAluminium Potassium Sulphate Dodecahydrate for cell culture, 99.5%, Endotoxin (BET) 0.05EU/mg
CAS:Formula:AlK(SO4)2·12H2OPurity:min. 99.5%Color and Shape:White, Crystalline powder / Crystals, Clear, ColourlessMolecular weight:474.38Concanavalin A Lectin ex. Canavalia Ensiformis Type 2 for cell culture, 20 ug/ml, (BET) 0.05EU/mg
CAS:Color and Shape:Off white, CompoundMarine Agar 2216 (Zobell)
Color and Shape:Cream, Free flowing, homogeneous powder, Slightly opalescent to opalescent, with slight precipitate, Slightly opalescent to opalescent, with slight precipitate, Light amberAsparagine Proline Broth BioVeg
Color and Shape:White, Free flowing, homogeneous powder, Clear solution without any precipitate, Clear solution without any precipitate, ColourlessTryptone Soya Agar (TSA) (Soyabean Casein Digest Agar, SCDA) BioVeg
Color and Shape:Light beige, Free flowing, homogeneous powder, ,MacConkey Agar Medium
Color and Shape:Pinkish beige, Free flowing, homogeneous powder, Orange red, Clear to slightly opalescentGelatin Agar DEV
Color and Shape:Beige, Free flowing, homogeneous powder, Clear to slightly opalescent, Clear to very slightly opalescent, Light to medium amberChristensen Citrate Agar
Color and Shape:Light pink, Free flowing, homogeneous powder, Very slightly opalescent, Very slightly opalescent, Orange redAyers and Johnson Agar (Stock Culture Agar)
Color and Shape:Light tan, Free flowing, homogeneous powder, Opalescent, Opalescent, Medium amberL-Alanine for cell culture, 99%, Endotoxin (BET) 0.05EU/mg
CAS:Formula:C3H7NO2Purity:min. 99%Color and Shape:White, Crystalline powder, Clear, ColourlessMolecular weight:89.09Tryptone Soya Broth (TSB) w/ 6.5% Sodium Chloride (Soyabean Casein Digest Medium (SCDM) w/ NaCl)
Color and Shape:Cream, Free flowing, homogeneous powder, Light amber, Clear without any precipitateSabouraud Maltose Broth
Color and Shape:Beige, Free flowing, homogeneous powder, Light amber, Very slightly opalescent, Light amber, ClearSDS Agar Base (ISO basis)
Color and Shape:Cream to yellow, Free flowing, homogeneous powder, Reddish purple, Clear to slightly opalescent0.1% Peptone Salt Solution Dehydrated
Color and Shape:Off white to cream, Free flowing, homogeneous powder, Light to medium amber, Clear ,without any precipitateß-Nicotinamide Adenine Dinucleotide (ß-NAD,DPN) for cell culture, 98%, Endotoxin (BET) 0.05EU/mg
CAS:Formula:C21H27N7O14P2Purity:min. 98.0%Color and Shape:White to off-white, Crystalline powder, Clear, Colourless to pale yellowMolecular weight:663.44Peptonized Milk (Peptonized SM Powder) BactoBio for microbiology
Color and Shape:Cream, Free flowing, homogeneous powder, Medium amber, clearBrilliant Green Agar w/ 1.2% Agar
Color and Shape:Beige to light pink, Free flowing, homogeneous powder, Greenish brown, Clear to slightly opalescent gelChromogenic Listeria Lipase-C Supplement (ISO basis)
Color and Shape:Colorless to light cream, LiquidBrilliant Green Sulfa Agar (B.G. Sulpha Agar)
Color and Shape:Pink, Free flowing, homogeneous powder, Very slightly to slightly opalescent, Slightly opalescent, Greenish brownArginine Dihydrolase Broth
Color and Shape:Cream to Yellowish-grey, Free flowing, homogeneous powder, Clear to slightly opalescent, Clear to very slightly opalescent, PurpleM-HPC Agar Base
Color and Shape:Light yellow, Free flowing, homogeneous powder, Clear to slightly opalescent, Clear to very slightly opalescent, Light yellowCetrimide Agar Base, Harmonized
Color and Shape:Light cream, Free flowing, homogeneous powder, Opalescent, Opalescent, Light amberWater Plate Count Agar (ISO basis)
Color and Shape:Beige, Free flowing, homogeneous powder, Medium amber, ClearSoyabean Casein Digest Agar (SCDA) (Tryptone Soya Agar, TSA)
Color and Shape:Light yellow, Free flowing, homogeneous powder, Clear to slightly opalescent, Clear to very slightly opalescent, Light yellow ( Note : If desired add defibrinated blood After addition of 5% sterile defibrinated blood: Cherry red, opaque.)MacConkey Agar w/o C.V., NaCl w/ 0.5% Sodium Taurocholate
Color and Shape:Pinkish beige, Free flowing, homogeneous powder, Clear to slightly opalescent, Clear to very slightly opalescent, Light red to redM17 Agar Base
Color and Shape:Cream coloured, Free flowing, homogeneous powder, Clear to slightly opalescent, Light to medium amber, Clear to very slightly opalescentTris Buffer for cell culture, 99.9%, Endotoxin (BET) 0.05 EU/mg
CAS:Controlled ProductFormula:C4H11NO3Purity:min. 99.9%Color and Shape:White, Crystalline powder, Clear, ColourlessMolecular weight:121.14MacConkey Agar w/ 0.15% Bile salts, C.V. and NaCl (USP Basis)
Color and Shape:Pinkish beige, Free flowing, homogeneous powder, Clear to slightly opalescent, Clear to very slightly opalescent, Red with purplish tingeHS Medium (Hydrosulphite of Sodium Medium)
Color and Shape:Cream, Free flowing, homogeneous powder, Light amber, clear to very slightly opalescent, Clear to very slightly opalescent, solution with upper 10% or less medium having pinkish tinge on standing, Light amber colouredPeptone BactoBio for bacteriology
CAS:Color and Shape:Light to medium tan, Free flowing,homogeneous powder, Light to medium amber, clearM17 Broth Base
Color and Shape:Cream colour, Free flowing, homogeneous powder, Clear to slightly opalescent, Clear to slightly opalescent, Light to medim amberMacConkey Broth Double Strength w/ Neutral Red
Color and Shape:Pinkish biege, Free flowing, homogeneous powder, Red, Clear without any precipitatePseudomonas Agar for Fluorescein
Color and Shape:Light beige, Free flowing, homogeneous powder, Clear to slightly opalescent, Clear to slightly opalescent, Light to medium amberBuffered Glycerol Saline Base
Color and Shape:Light yellow to pink, Free flowing, homogeneous powder, Light pink, Clear solution without any precipitateStarch Agar
Color and Shape:Light cream, Free flowing, homogeneous powder, Very slightly opalescent, Very slightly opalescent, Light amberAseptic Commissioning Medium (Aseptic Packing Line Medium)
Color and Shape:Biege to pink, Free flowing, homogeneous powder., Clear, Orange-red, Clear without any precipitateTryptone Type II (Casitose) BactoBio for bacteriology
Color and Shape:Cream, Free flowing ,homogeneous powder, Light to medium amber, clearTryptose Cycloserine Dextrose Agar Base
Color and Shape:Beige w/brownish tint, Free, flowing homogeneous powder, Slightly opalescent, Light amber, Clear to slightly opalescentAsparagine Nitrate Medium
Color and Shape:White to cream, Free flowing, homogeneous powder, Clear to slightly opalescent, Clear to very slightly opalescent, Light to medium amberEMB Agar, Levine
Color and Shape:Light purple, Free flowing, homogeneous powder, Reddish Purple, Slightly opalescent with greenish cast and finely dispersed precipitateMannitol Nitrate Motility Medium
Color and Shape:Pink - orange, Free flowing, homogeneous powder, Reddish pink, Clear to very slightly opalescentBlood Agar Base
Color and Shape:Yellow, Free flowing, homogeneous powder, Clear to slightly opalescent, Clear to slightly opalescent,Heart Infusion Powder (HI Powder) BactoBio for bacteriology
Color and Shape:Brownish yellow, Free, flowing homogeneous powder, Light to medium amber, clearBIGGY Agar (Nickerson Medium)
Color and Shape:Light beige, Free flowing, homogeneous powder, Opalescent with a flocculent precipitate, Opalescent with a flocculent precipitate, Very light to light amberAsparagine Proline Broth
Color and Shape:White, Free flowing, homogeneous powder, Clear solution without any precipitate, Clear solution without any precipitate, Colourlessr-Trypsin - Type Standard ACF ex. Porcine for cell culture, 800U/mg, Endotoxin (BET) 0.05EU/mg
CAS:Color and Shape:Tan to pale brown, Granular powderIMViC Test Kit (Pre-Weighed Media) w/ Reagents
Color and Shape:Light cream, free flowing, homogeneous powder, Light amber, clear, Cream, free flowing, homogeneous powder, Light amber, clear, Mustard yellow, free flowing, homogeneous powder, Forest green, clear to slightly opalescentViolet Red Bile Glucose Agar, Harmonized
Color and Shape:Beige, Free flowing, homogeneous powder, Clear to slightly opalescent, Clear to very slightly opalescent, Reddish purplePotato Carrot Broth
Color and Shape:Cream to yellow, Free flowing, homogeneous powder, Yellow with red tinge, Clear to very slightly opalescentMacConkey Agar No.3
Color and Shape:Pinkish beige, Free flowing, homogeneous powder, Slightly opalescent, Slightly opalescent, Reddish purpleAmies Transport Medium w/o Charcoal
Color and Shape:Biege, Free flowing, homogeneous powder, Clear to slightly opalescent with slight precipitate, Clear to slightly opalescent with slight precipitate, Colourless to light amberSIM Medium BioVeg
Color and Shape:Creamish tan, Free flowing, homogeneous powder, Clear to very slightly opalescent, Clear to very slightly opalescent, Medium amberFungal Agar (Mycological Agar)
Color and Shape:Light beige, Free flowing, homogeneous powder, Light to medium amber, Clear to slightly opalescentDeoxycholate Agar
Color and Shape:Pinkish beige, Free flowing, homogeneous powder, Clear to slightly opalescent with no significant precipitate, Clear to very slightly opalescent with no significant precipitate, Reddish orangeDichloran Glycerol Medium Base
Color and Shape:Beige, Free flowing , homogeneous powder., Medium amber, Clear to slightly opalescentR3A Agar
Color and Shape:Cream to yellow, Free flowing, homogeneous powder, Slightly opalescent gel, Clear to slightly opalescent gel, Light yellow colouredViolet Red Bile Glucose Agar (ISO Basis)
Color and Shape:Beige with pinkish tinge, Free flowing, homogeneous powder, Clear to very slightly opalescent, Clear to very slightly opalescent, Reddish purple